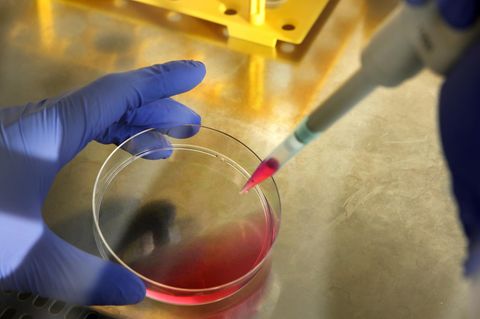

Eine Gentherapie verhilft rot-grün- blinden Totenkopfäffchen noch im Erwachsenenalter zum Farbensehen. Das berichtet ein amerikanisches Forscherteam um Katherine Mancuso von der Universität Washington im Fachjournal "Nature". Die Ergebnisse machen Hoffnung auf neue Behandlungswege bei Sehstörungen auch für erwachsene Menschen, schreiben die Forscher.
Männliche Totenkopfäffchen (Saimiri sciureus) sind von Natur aus farbenblind. Ihnen fehlen die Sinneszellen für bestimmte Wellenlängen des Lichts, daher erkennen sie nur Gelb und Blau und können viele Rot- und Grüntöne nicht von Grau unterscheiden. Nur einige weibliche Tiere sehen dreifarbig, da sie die erforderlichen Farbkörper, sogenannte Pigmente, in der Netzhaut besitzen.
Auch ein erwachsenes Gehirn kann sich anpassen
Farbenblindheit tritt auf, wenn das sogenannte L-Opsin-Gen fehlt, das für die Bildung bestimmter Pigmente verantwortlich ist. Mancuso und ihre Kollegen injizierten ein menschliches L-Opsin-Gen in die lichtempfindliche Schicht unter die Netzhaut der farbenblinden Primaten. Anschließende Farbtests zeigten, dass die Tiere etwa 20 Wochen nach der Behandlung imstande waren, dreifarbig zu sehen. Die neue Fähigkeit hielt auch zwei Jahre nach der Gentherapie weiter an. Bislang dachte man, dass angeborene Sehstörungen lediglich bei sehr jungen Menschen behandelt werden können, da deren Gehirn noch ausreichend flexibel ist, um sich an die veränderte Wahrnehmung anzupassen. Die vorliegenden Ergebnisse zeigen jedoch, dass zum dreifarbigen Sehen lediglich die richtigen Pigmente erforderlich sind, sagen die Wissenschaftler. Auch ein erwachsenes Gehirn könne die neuen Informationen verarbeiten. Das zeige das große Potenzial der Gentherapie zur Wiederherstellung nicht vorhandener oder verlorener Sehleistung, so die Forscher.